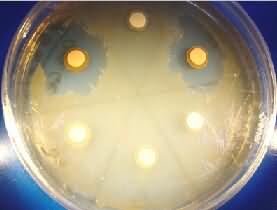

Test auf Bildung von Hemmstoffen. Die Farbstoff bildenden
Bakterien scheiden Substanzen aus, die das Wachstum eines
Teststamms (als trüber Bakterienrasen erkennbar) hemmen.
| Hier wurden marine Bakterien gefunden, die einen neuen Wirkstoff bilden, der vielleicht einmal als Antibiotikum in der Medizin genutzt werden könnte. Die Struktur des Stoffes wurde bereits aufgeklärt. |